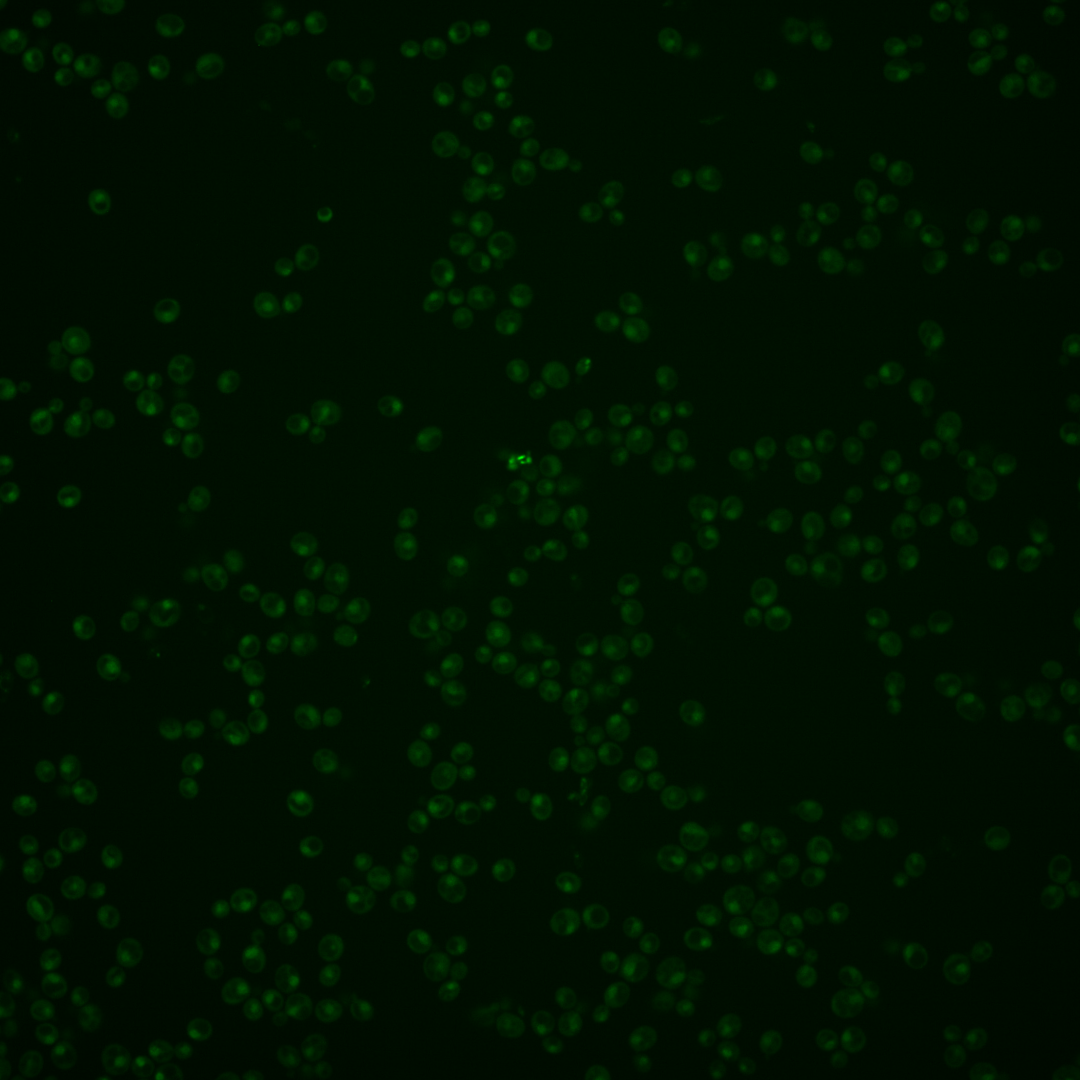
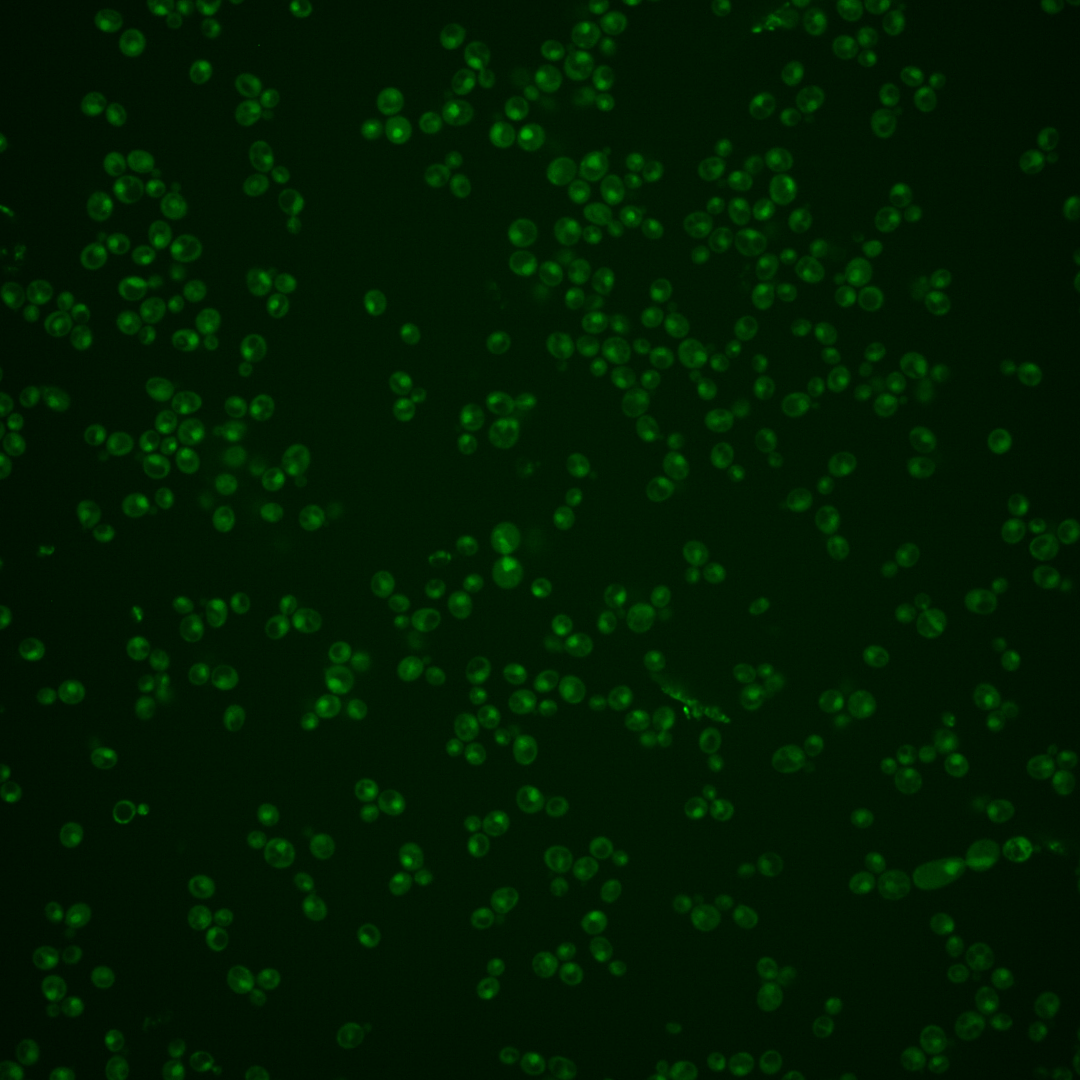

| Standard name | |
|---|---|
| Human Ortholog | |
| Description | Transcription factor; activated by proteolytic processing in response to signals from the SPS sensor system for external amino acids; activates transcription of amino acid permease genes; STP2 has a paralog, STP1, that arose from the whole genome duplication |
Micrographs




















































































Sub-cellular Localization
Yeast GFP Assignment
Protein Abundance
Localization Change
External localization resources
| ensLOC | DeepLoc | |||||||||||||||||||||||
|---|---|---|---|---|---|---|---|---|---|---|---|---|---|---|---|---|---|---|---|---|---|---|---|---|
| Localization | WT1 | WT2 | WT3 | RAP60 | RAP140 | RAP220 | RAP300 | RAP380 | RAP460 | RAP540 | RAP620 | RAP700 | HU80 | HU120 | HU160 | rpd3Δ_1 | rpd3Δ_2 | rpd3Δ_3 | WT1 | WT2 | WT3 | AF100 | AF140 | AF180 |
| Cortical Patches | 0 | 0 | 0 | 0 | 0 | 0 | 0 | 1 | 0 | 0 | 0 | 0 | 0 | 0 | 0 | 0 | 0 | 0 | 0 | 0 | 2 | 0 | 2 | 1 |
| Bud | 0 | 0 | 4 | 4 | 0 | 3 | 1 | 7 | 11 | 5 | 2 | 2 | 0 | 0 | 0 | 0 | 0 | 0 | 2 | 5 | 4 | 3 | 7 | 18 |
| Bud Neck | 0 | 0 | 2 | 0 | 1 | 0 | 0 | 2 | 1 | 2 | 1 | 0 | 0 | 0 | 0 | 0 | 1 | 0 | 0 | 1 | 3 | 2 | 7 | 8 |
| Bud Site | 0 | 1 | 0 | 0 | 0 | 1 | 4 | 1 | 2 | 1 | 0 | 2 | 1 | 0 | 0 | 0 | 0 | 0 | – | – | – | – | – | – |
| Cell Periphery | 0 | 0 | 0 | 0 | 0 | 0 | 0 | 0 | 0 | 1 | 0 | 0 | 0 | 0 | 0 | 1 | 0 | 0 | 0 | 0 | 0 | 0 | 0 | 0 |
| Cytoplasm | 5 | 19 | 35 | 147 | 138 | 96 | 138 | 203 | 152 | 182 | 57 | 77 | 40 | 105 | 221 | 165 | 78 | 73 | 1 | 3 | 42 | 69 | 219 | 99 |
| Endoplasmic Reticulum | 0 | 0 | 2 | 0 | 0 | 1 | 0 | 0 | 0 | 2 | 1 | 0 | 0 | 1 | 0 | 39 | 17 | 13 | 0 | 0 | 1 | 0 | 2 | 4 |
| Endosome | 2 | 3 | 1 | 0 | 2 | 0 | 0 | 1 | 0 | 0 | 0 | 0 | 3 | 19 | 30 | 82 | 40 | 11 | 4 | 8 | 8 | 6 | 3 | 6 |
| Golgi | 0 | 0 | 0 | 0 | 0 | 0 | 0 | 0 | 0 | 0 | 0 | 0 | 0 | 0 | 0 | 0 | 1 | 1 | 2 | 2 | 1 | 0 | 0 | 0 |
| Mitochondria | 32 | 28 | 84 | 34 | 51 | 75 | 172 | 188 | 185 | 246 | 96 | 89 | 10 | 10 | 4 | 69 | 15 | 17 | 2 | 6 | 19 | 4 | 12 | 7 |
| Nucleus | 86 | 196 | 48 | 1 | 1 | 3 | 6 | 12 | 8 | 17 | 5 | 5 | 135 | 64 | 9 | 155 | 155 | 136 | 82 | 220 | 83 | 35 | 26 | 28 |
| Nuclear Periphery | 0 | 0 | 0 | 0 | 0 | 0 | 2 | 0 | 0 | 0 | 0 | 0 | 0 | 0 | 0 | 0 | 0 | 0 | 1 | 0 | 2 | 0 | 1 | 0 |
| Nucleolus | 14 | 13 | 0 | 0 | 2 | 1 | 0 | 0 | 0 | 0 | 0 | 1 | 2 | 0 | 1 | 5 | 1 | 1 | 11 | 13 | 7 | 4 | 3 | 1 |
| Peroxisomes | 0 | 0 | 0 | 0 | 0 | 0 | 0 | 0 | 0 | 0 | 0 | 0 | 0 | 1 | 0 | 1 | 0 | 0 | 0 | 0 | 1 | 0 | 0 | 0 |
| SpindlePole | 1 | 0 | 2 | 1 | 1 | 0 | 1 | 5 | 5 | 0 | 0 | 0 | 0 | 0 | 1 | 27 | 12 | 1 | 4 | 15 | 20 | 14 | 19 | 18 |
| Vac/Vac Membrane | 8 | 37 | 28 | 4 | 16 | 5 | 8 | 11 | 10 | 5 | 1 | 3 | 20 | 74 | 79 | 103 | 58 | 43 | 9 | 40 | 51 | 24 | 29 | 46 |
| Unique Cell Count | 111 | 269 | 180 | 172 | 186 | 147 | 261 | 341 | 287 | 362 | 132 | 141 | 199 | 253 | 305 | 516 | 327 | 257 | 124 | 322 | 261 | 177 | 348 | 252 |
| Labelled Cell Count | 148 | 297 | 206 | 191 | 212 | 185 | 332 | 431 | 374 | 461 | 163 | 179 | 211 | 274 | 345 | 647 | 378 | 296 | 124 | 322 | 261 | 177 | 348 | 252 |
Yeast GFP Assignment
Protein Abundance
| Screen | WT1 | WT2 | WT3 | RAP60 | RAP140 | RAP220 | RAP300 | RAP380 | RAP460 | RAP540 | RAP620 | RAP700 | HU80 | HU120 | HU160 | rpd3Δ_1 | rpd3Δ_2 | rpd3Δ_3 | AF100 | AF140 | AF180 |
|---|---|---|---|---|---|---|---|---|---|---|---|---|---|---|---|---|---|---|---|---|---|
| Mean Cell GFP Intensity (1e-4) | 4.7 | 5.1 | 3.8 | 3.3 | 3.6 | 3.1 | 2.6 | 3.0 | 2.9 | 2.6 | 2.6 | 2.6 | 5.6 | 4.9 | 4.8 | 5.6 | 6.6 | 6.5 | 4.4 | 4.4 | 5.6 |
| Std Deviation (1e-4) | 0.7 | 1.0 | 0.6 | 1.0 | 1.3 | 1.1 | 1.0 | 0.8 | 0.9 | 0.6 | 0.5 | 0.8 | 1.2 | 1.0 | 1.5 | 1.5 | 1.5 | 1.6 | 1.2 | 1.1 | 1.9 |
| Intensity Change (Log2) | – | – | – | -0.19 | -0.08 | -0.3 | -0.56 | -0.36 | -0.42 | -0.57 | -0.54 | -0.57 | 0.55 | 0.37 | 0.33 | 0.55 | 0.79 | 0.78 | 0.22 | 0.2 | 0.54 |
Localization Change
| Localization | RAP60 | RAP140 | RAP220 | RAP300 | RAP380 | RAP460 | RAP540 | RAP620 | RAP700 | HU80 | HU120 | HU160 | rpd3Δ_1 | rpd3Δ_2 | rpd3Δ_3 |
|---|---|---|---|---|---|---|---|---|---|---|---|---|---|---|---|
| Cortical Patches | 0 | 0 | 0 | 0 | 0 | 0 | 0 | 0 | 0 | 0 | 0 | 0 | 0 | 0 | 0 |
| Bud | 0 | 0 | 0 | 0 | 0 | 0 | 0 | 0 | 0 | 0 | 0 | 0 | 0 | 0 | 0 |
| Bud Neck | 0 | 0 | 0 | 0 | 0 | 0 | 0 | 0 | 0 | 0 | 0 | 0 | 0 | 0 | 0 |
| Bud Site | 0 | 0 | 0 | 0 | 0 | 0 | 0 | 0 | 0 | 0 | 0 | 0 | 0 | 0 | 0 |
| Cell Periphery | 0 | 0 | 0 | 0 | 0 | 0 | 0 | 0 | 0 | 0 | 0 | 0 | 0 | 0 | 0 |
| Cytoplasm | 12.4 | 10.5 | 8.4 | 7.1 | 8.7 | 7.2 | 6.9 | 4.5 | 6.6 | 0.2 | 4.8 | 11.3 | 3.2 | 1.1 | 2.1 |
| Endoplasmic Reticulum | 0 | 0 | 0 | 0 | 0 | 0 | 0 | 0 | 0 | 0 | 0 | 0 | 3.2 | 2.3 | 2.2 |
| Endosome | 0 | 0 | 0 | 0 | 0 | 0 | 0 | 0 | 0 | 0 | 3.4 | 0 | 5.5 | 4.6 | 0 |
| Golgi | 0 | 0 | 0 | 0 | 0 | 0 | 0 | 0 | 0 | 0 | 0 | 0 | 0 | 0 | 0 |
| Mitochondria | 0 | 0 | 0 | 0 | 0 | 0 | 0 | 0 | 0 | -9.4 | -10.6 | 0 | -9.3 | -11.4 | -9.8 |
| Nucleus | -7.1 | -7.3 | -6.1 | -7.7 | -7.9 | -7.7 | -7.4 | -5.3 | -5.5 | 8.0 | -0.3 | -7.8 | 0.9 | 4.6 | 5.5 |
| Nuclear Periphery | 0 | 0 | 0 | 0 | 0 | 0 | 0 | 0 | 0 | 0 | 0 | 0 | 0 | 0 | 0 |
| Nucleolus | 0 | 0 | 0 | 0 | 0 | 0 | 0 | 0 | 0 | 0 | 0 | 0 | 0 | 0 | 0 |
| Peroxisomes | 0 | 0 | 0 | 0 | 0 | 0 | 0 | 0 | 0 | 0 | 0 | 0 | 0 | 0 | 0 |
| SpindlePole | 0 | 0 | 0 | 0 | 0 | 0 | 0 | 0 | 0 | 0 | 0 | 0 | 2.4 | 0 | 0 |
| Vacuole | -4.3 | -2.0 | -3.6 | -4.7 | -5.1 | -4.6 | -6.5 | -4.4 | -4.0 | -1.6 | 3.3 | 2.7 | 1.3 | 0.6 | 0.3 |
External localization resources
Images






























Protein Concentration and Protein Localization Data
| R1 | R2 | R3 | ||||||||||||||||
|---|---|---|---|---|---|---|---|---|---|---|---|---|---|---|---|---|---|---|
| G1 Pre-START | G1 Post-START | S/G2 | Metaphase | Anaphase | Telophase | G1 Pre-START | G1 Post-START | S/G2 | Metaphase | Anaphase | Telophase | G1 Pre-START | G1 Post-START | S/G2 | Metaphase | Anaphase | Telophase | |
| Concentration | – | – | – | – | – | – | – | – | – | – | – | – | – | – | – | – | – | – |
| Actin | – | – | – | – | – | – | 0.1013 | 0.0002 | 0.0253 | 0.0003 | 0.0001 | 0.0013 | 0.0821 | 0.0188 | 0.0035 | 0.0007 | 0.1071 | 0.0023 |
| Bud | – | – | – | – | – | – | 0.0005 | 0.0001 | 0.001 | 0 | 0 | 0.0007 | 0.0009 | 0.0007 | 0.0006 | 0.0002 | 0.0003 | 0.0007 |
| Bud Neck | – | – | – | – | – | – | 0.0009 | 0.0006 | 0.0024 | 0.0002 | 0.0004 | 0.0055 | 0.0272 | 0.0004 | 0.0007 | 0.0015 | 0.0099 | 0.0055 |
| Bud Periphery | – | – | – | – | – | – | 0.0004 | 0.0001 | 0.0014 | 0 | 0 | 0.0019 | 0.0069 | 0.0007 | 0.001 | 0.0007 | 0.0007 | 0.0022 |
| Bud Site | – | – | – | – | – | – | 0.0031 | 0.0007 | 0.0037 | 0.0001 | 0.0001 | 0.0033 | 0.0024 | 0.0102 | 0.0068 | 0.0004 | 0.0026 | 0.0006 |
| Cell Periphery | – | – | – | – | – | – | 0.0001 | 0 | 0.0002 | 0 | 0 | 0.0002 | 0.0031 | 0.0001 | 0.0003 | 0.0001 | 0.0023 | 0.0001 |
| Cytoplasm | – | – | – | – | – | – | 0.0231 | 0.026 | 0.0156 | 0.0345 | 0.0521 | 0.0174 | 0.0062 | 0.027 | 0.0227 | 0.0245 | 0.0353 | 0.0196 |
| Cytoplasmic Foci | – | – | – | – | – | – | 0.0667 | 0.0002 | 0.008 | 0.0003 | 0.0062 | 0.0091 | 0.0268 | 0.0059 | 0.0075 | 0.0009 | 0.0021 | 0.0036 |
| Eisosomes | – | – | – | – | – | – | 0.0003 | 0 | 0.0001 | 0 | 0 | 0 | 0.0003 | 0.0002 | 0.0002 | 0.0001 | 0.0007 | 0.0001 |
| Endoplasmic Reticulum | – | – | – | – | – | – | 0.0021 | 0.0009 | 0.0007 | 0.0006 | 0.0039 | 0.0008 | 0.0023 | 0.0018 | 0.0008 | 0.0012 | 0.0241 | 0.0008 |
| Endosome | – | – | – | – | – | – | 0.0277 | 0.0005 | 0.0126 | 0.0005 | 0.0086 | 0.0087 | 0.006 | 0.0197 | 0.0045 | 0.0057 | 0.0051 | 0.0037 |
| Golgi | – | – | – | – | – | – | 0.0116 | 0 | 0.0067 | 0 | 0.0001 | 0.0019 | 0.0073 | 0.0096 | 0.0033 | 0.0013 | 0.0017 | 0.0024 |
| Lipid Particles | – | – | – | – | – | – | 0.0326 | 0 | 0.0085 | 0 | 0.0021 | 0.0025 | 0.0248 | 0.0022 | 0.0037 | 0.001 | 0.0026 | 0.0012 |
| Mitochondria | – | – | – | – | – | – | 0.0027 | 0.0005 | 0.0116 | 0.0003 | 0.0002 | 0.002 | 0.0071 | 0.0043 | 0.0107 | 0.034 | 0.0017 | 0.0036 |
| None | – | – | – | – | – | – | 0.0093 | 0.0518 | 0.0064 | 0.0548 | 0.0614 | 0.0164 | 0.0018 | 0.0101 | 0.0421 | 0.0572 | 0.0259 | 0.0185 |
| Nuclear Periphery | – | – | – | – | – | – | 0.0068 | 0.0181 | 0.0109 | 0.0092 | 0.0127 | 0.0071 | 0.0047 | 0.0116 | 0.0143 | 0.0053 | 0.0043 | 0.0059 |
| Nucleolus | – | – | – | – | – | – | 0.0043 | 0.0055 | 0.0068 | 0.0021 | 0.0059 | 0.0134 | 0.0077 | 0.0053 | 0.0046 | 0.0062 | 0.0186 | 0.0105 |
| Nucleus | – | – | – | – | – | – | 0.5876 | 0.8604 | 0.7924 | 0.889 | 0.785 | 0.8762 | 0.6627 | 0.8635 | 0.8301 | 0.8401 | 0.7456 | 0.8952 |
| Peroxisomes | – | – | – | – | – | – | 0.0434 | 0 | 0.0125 | 0 | 0.0001 | 0.0025 | 0.0577 | 0.0012 | 0.0183 | 0.0002 | 0.0014 | 0.0006 |
| Punctate Nuclear | – | – | – | – | – | – | 0.0744 | 0.0331 | 0.0708 | 0.0077 | 0.0598 | 0.0255 | 0.0538 | 0.0045 | 0.023 | 0.014 | 0.0039 | 0.0213 |
| Vacuole | – | – | – | – | – | – | 0.0009 | 0.0008 | 0.0015 | 0.0002 | 0.0008 | 0.0031 | 0.0069 | 0.0017 | 0.001 | 0.0024 | 0.0036 | 0.0013 |
| Vacuole Periphery | – | – | – | – | – | – | 0.0004 | 0.0002 | 0.0006 | 0.0001 | 0.0002 | 0.0005 | 0.0011 | 0.0006 | 0.0003 | 0.0023 | 0.0005 | 0.0004 |
Sequencing Data
| R1 | R2 | |||||||||
|---|---|---|---|---|---|---|---|---|---|---|
| G1 Post-START | S/G2 | Metaphase | Anaphase | Telophase | G1 Post-START | S/G2 | Metaphase | Anaphase | Telophase | |
| Gene Expression | 15.2685 | 15.7723 | 13.0542 | 14.2051 | 18.4765 | 12.8863 | 17.3274 | 21.5268 | 17.7196 | 21.9353 |
| Translational Efficiency | 1.3876 | 1.5501 | 1.2204 | 1.0984 | 1.2085 | 1.7698 | 1.2988 | 0.9401 | 1.121 | 1.2357 |
Hit Data
| Dataset | Hit |
|---|---|
| Protein Concentration | – |
| Protein Localization | ✘ |
| Gene Expression | ✘ |
| Translational Efficiency | ✘ |
Endocytosis
| Temp | Actin Patch (Sac6-tdTomato) | Cortical Patch (Sla1-GFP) | Late Endosome (Snf7-GFP) | Vacuole (Vph1-GFP) |
|---|---|---|---|---|
| 37℃ | ||||
| RT |
Cell Cycle Omics
CYCLoPs (Stp2-GFP)
| Gene / Allele | Actin Patch (Sac6-tdTomato) | Cortical Patch (Sla1-GFP) | Late Endosome (Snf7-GFP) | Vacuole (Sac6-tdTomato) |
|---|
| Gene | Images |
|---|
| Gene | Images |
|---|
Images are not yet available
Images are not yet available